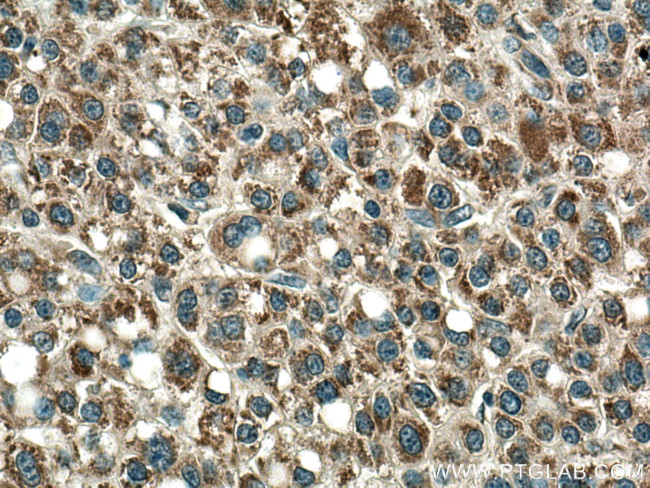
PCCA Antibody in Immunohistochemistry (Paraffin) (IHC (P))
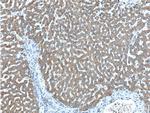
PCCA Antibody in Immunohistochemistry (Paraffin) (IHC (P))

Search
Proteintech
PCCA Polyclonal Antibody
{{$productOrderCtrl.translations['antibody.pdp.commerceCard.promotion.promotions']}}
{{$productOrderCtrl.translations['antibody.pdp.commerceCard.promotion.viewpromo']}}
{{$productOrderCtrl.translations['antibody.pdp.commerceCard.promotion.promocode']}}: {{promo.promoCode}} {{promo.promoTitle}} {{promo.promoDescription}}. {{$productOrderCtrl.translations['antibody.pdp.commerceCard.promotion.learnmore']}}
产品信息
21988-1-AP
种属反应
已发表种属
宿主/亚型
分类
类型
抗原
偶联物
形式
浓度
规格
纯化类型
保存液
内含物
保存条件
运输条件
产品详细信息
This antibody is specific to PCCA.
Immunogen sequence: LVQEMIRVA KGYPLRHKQA DIRINGWAVE CRVYAEDPYK SFGLPSIGRL SQYQEPLHLP GVRVDSGIQP GSDISIYYDP MISKLITYGS DRTEALKRMA DALDNYVIRG VTHNIALLRE VIINSRFVKG DISTKFLSDV YPDGFKGHML TKSEKNQLLA IASSLFVAFQ LRAQHFQENS RMPVIKPDIA NWELSVKLHD KVHTVVASNN GSVFSVEVDG SKLNVTSTWN LASPLLSVSV DGTQRTVQCL SREAGGNMSI QFLGTVYKVN ILTRLAAELN KFMLEKVTED TSSVLRSPMP GVVVAVSVKP GDAVAEGQEI CVIEAMKMQN SMTAGKTGTV KSVHCQAGDT VGEGDLLVEL E (344-703 aa encoded by BC000140)
靶标信息
This protein is a key enzyme in the catabolic pathway of odd-chain fatty acids, isoleucine, threonine, methionine, and valine. It is probably a dodecamer composed of six biotin-containing alpha subunits and six beta subunits. The protein is located in the mitochondrial matrix. Defects in PCCA are the cause o propionic acidemia type I (PA-1). PA-1 is a life-threatening disease characterized by episodic vomiting, lethargy and ketosis, neutropenia, periodic thrombocytopenia, hypogammaglobulinemia, develop-mental retardation, and intolerance to protein.
仅用于科研。不用于诊断过程。未经明确授权不得转售。
生物信息学
蛋白别名: metastasis-associated gene; pccA complementation group; PCCase alpha subunit; PCCase subunit alpha; propanoyl-CoA:carbon dioxide ligase alpha subunit; Propanoyl-CoA:carbon dioxide ligase subunit alpha; propionyl CoA carboxylase, alpha polypeptide; propionyl CoA-carboxylase alpha; Propionyl Coenzyme A carboxylase alpha polypeptide; propionyl Coenzyme A carboxylase, alpha polypeptide; propionyl-CoA carboxylase; propionyl-CoA carboxylase alpha chain (EC 6.4.1.3); Propionyl-CoA carboxylase alpha chain, mitochondrial; propionyl-CoA carboxylase alpha subunit; propionyl-coenzyme A carboxylase, alpha polypeptide; RP11-151A6.1; unnamed protein product
基因别名: C79630; PCCA
UniProt ID: (Human) P05165, (Rat) P14882, (Mouse) Q91ZA3
Entrez Gene ID: (Human) 5095, (Rat) 687008, (Mouse) 110821